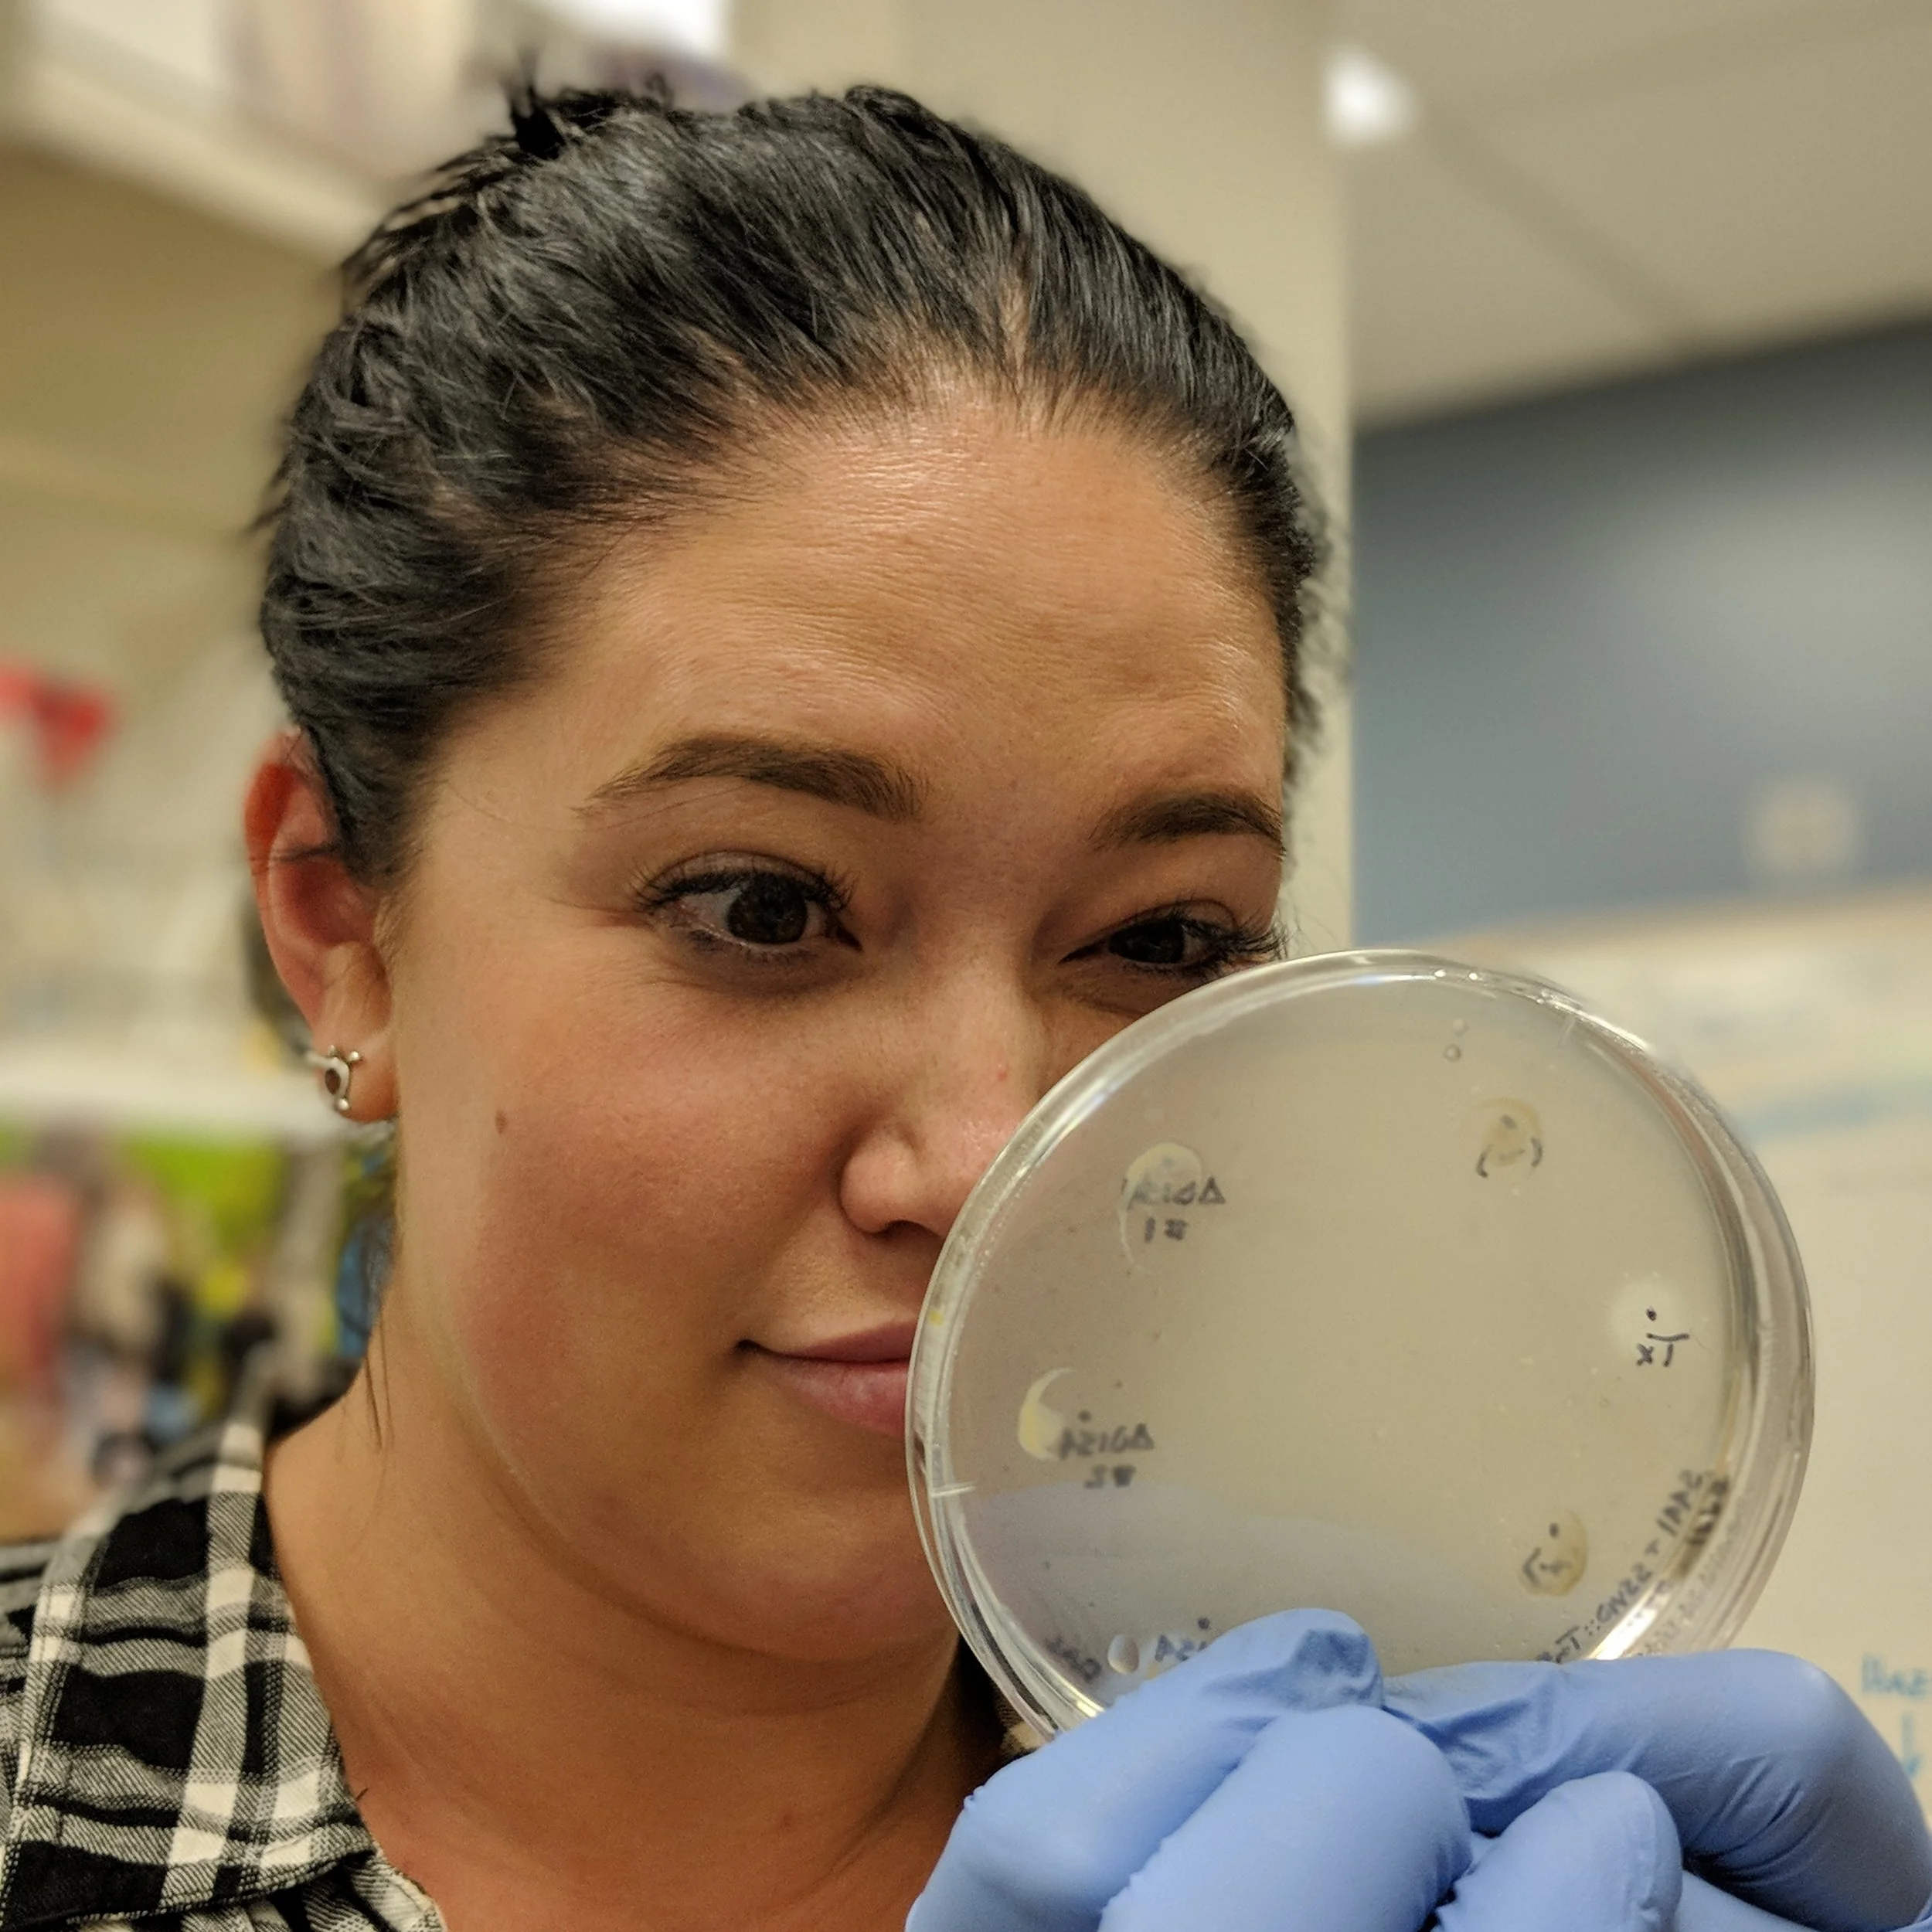

The extreme virus lab (xvl) Team
The team from the 2023 trip to Lassen Volcanic National Park
The team from the 2018 trip to Lassen Volcanic National Park
Principal investigator
Ken Stedman Ph.D.
Principal Investigator
B.S. Chemical Engineering, Stanford, 1987
Ph.D. Molecular & Cell Biology, UC Berkeley, 1996
Virus hunter, science communicator, and money grubber.
Being a Dad, biker, and trying not to grow up.
personnel
Ignacio "Nacho" de la Higuera, Ph.D. Research Associate
B.S. Biology, University of Granada, Spain, 2008
Ph.D Molecular Biology, Autonomous University of Madrid, Spain, 2014
Virus Origins and Evolution. Cruciviruses. Fuselloviruses.
Tato-pani enthusiat. Onsen-connoisseur. Playing drums and weirdo music.
Graduate Researchers
Jono Abshier
B. S. Biomedical Science, University of Texas Rio Grande Valley, 2019
Doctoral Candidate, Portland State University - Biology
SSVs and Saccharolobus. Leisure reading, mushroom hunting, cooking and dancing when no one is watching in lab.
Undergraduate Researchers
David Weiyi Noeckel
B. A. Biochemistry and Molecular Biology, Reed College, 2020
Doctoral Candidate, Portland State University - Biology
Crucivirus Replication protein and DNA biochemistry. Cat-wrangling, sketching, cooking dim sum, and pulling noodles.
Marius Brasted-Maki
Career Pathway Certificate: Advanced Bioscience Technologist
Pursuing a B.S. in Biology
Marius is working on Glycosylation in SSV1 major capsid protein. Making collages, swimming, cooking, and watching Star Trek are some of Marius’ favorite things!
Friends of the Lab
Brenda Watt
Ph.D. University of Pennsylvania
Previously Senior Scientist, Stonestable, Inc., now Refeyn Ltd.
Worked to develop a marketable vaccine preservation method using silica for Dr. Stedman's startup company StoneStable, Inc.
John Howieson
M.D. U. Kansas
Dr. Howieson, a retired physician, has never stopped learning, and continues to attend classes at Portland State. He is also a good friend of the lab and extremely generous patron of our research and the Biology department.
Previous students and lab members
David Schwartz
The Chief Cryptographer at Ripple, a popular cryptocurrency, Dave is a friend and supporter of the Stedman Lab.
Allison Stenger
Ph.D.
George Kasun
B.S. Biology, 20??, UC Davis
Ph.D. 2021
BSL-RDV Rep protein.
Fishing a lot.
David Goodman
B.S. Biology, Portland State, 2014
M.S. Biology, Portland State, 2018
Genomic characterization and most things pertaining to SSV1 & SSV10.
Don't talk to me I'm singing. Now Laboratory Preparator, Portland State University.
Nichole Procter
B.S. Biology, Portland State, 2020
SSV mutants.
Gardening and being a mom to three chihuahuas.
Ph.D. Program at U.C. Irvine.
Ellis Torrance
B.S. Biology, Portland State, 2018
2018 McNair Scholar
In the Stedman lab worked on Crucivirus host elucidation.
Now a DOE Computational Science Fellow in Ph.D. program at UNC Greensboro.
Sara Protzek
B.S. Biology, Portland State, 2017
In the Stedman Lab, Sara worked with Cruciviruses. She now works as a lab technician at Oregon Health and Science University.
Max Larson
B.S. Biology, Portland State, 2016
BSL-RDHV Rep protein expression.
Hiking and hanging out with my cat.
Clinical Medical Technology
Rita Clare
B.S. Biology, Portland State, 2018
B.S. Industrial Design, University of Oregon, 2014
SSV capsid expression, virus purification, Cas4 cloning and expression. Now working at the National Renewable Energy Research Laboratory in Golden, Colorado.
NSF GRFP Recipient 2020. Ph.D. program at Montana State University
Thymara van Kuringen
B.S. Applied Science, 2018
Fontys University of Applied Sciences, Netherlands
International Undergraduate Student
SSV1 mutant quantification using qPCR.
Biking and swimming (essential for a Dutch person)
Lorenzo Carré
Former International Masters Student from France who worked on SSV infectivity quantification.
Jane Arterberry
Patrizia Lynnel Alpapara
Hunter McCorkle
Jenni Tran
Thejanee Liyanaarchchi, DO student
Suzie Wallace, Graduate Student, Portland State
George Kasun, Senior Scientist, AbSci
Courtney Micheletti, Research Technician, OHSU.
Nichole Procter, Ph.D. Program in Neuroscience, U.C. Irvine.
Max Larson, OIT/OHSU Medical Technology Program.
Audrey Houlis, University of the Pacific
Diana Demchenko, Agricultural Technologist, Sebastapol, California.
Will Thayer, Reed College
Baylee Russell, REU student, previously research technician at UCSD, moving to Ph.D. program at Harvard.
Alyssa Pratt, High School Student, Apprenticeship in Science and Engineering Program, Presidential Scholar at Oregon State U.
Anna Lipari, High School Student, now at Grinnell College.
Thymara van Kuringen, International Undergraduate Student, B.S. Applied Science, 2018. Fontys University of Applied Sciences, Netherlands
David Goodman, MS, PSU Biology, 2018. Biology Laboratory Preparator, Robertson-Collaborative Life Science Building, Portland State University.
Ellis Torrance, Undergraduate Student, Cruci-consultant, currently Ph.D. Student, UNC Greensboro.
Rita Clare, Undergraduate Student, currently at the National Renewable Energy Laboratory, Golden, CO
Camden Hoover, REU Student, Newman University
Anh Le-Cook, Undergraduate Student, VA Medical Center, Portland.
Lorenzo Carré, International Masters Student, France
Lea Garzotto, High School Student, St. Mary's Academy
Amelia Alonzo, High School Student, St. Mary's Academy
Sara Protzek, Undergraduate Student, OHSU
Swati Pandruvada, REU Student, College of Medicine and Life Sciences, University of Toledo, MD program.
Angela Van Ecken, Undergraduate Build EXITO Student
Geoff Diemer, Graduate Student (Ph.D.), Vir Biotechnolgies
Eric Iverson, Graduate Student (Ph.D.)
Jim Laidler, Graduate Student (M.D., Ph.D.)
Megan Baglein, Undergraduate Student
Claire Couch, Undergraduate Student, Ph.D. program Oregon State U.
Nkolika Egbukichi, Undergraduate Student, MD/Ph.D. U.Colorado
Jeremy Filip, Undergraduate Student
Nick Kosmicki, Undergraduate Student
Madeline Laws, Undergraduate Student
Damon McNiel, Undergraduate Student
Kaltuma Mohamed Nader, Undergraduate Student, Yale
Brownie Tuiasosopo, Undergraduate Student, MD
Jennifer Kyle, NASA Astrobiology Institute Postdoctoral Fellow, at Pacific Northwest National Lab.
Adam Clore,Graduate Student (Ph.D.), Postdoc at OHSU, Staff Scientist, IDT.
Dissertation: The Family Fuselloviridae: Diversity and Replication of a Hyperthermic Virus Infecting the Archaeon Genus Sulfolobus.
Melissa DeYoung, Graduate Student (M.Sc.)
Johanna Rigas, Graduate Student (M.Sc.), D.Vm. OSU, 2008.
Shannon Adams, Undergraduate Student
Holly Bradford, Undergraduate Student, Providence Health System
Rebecca (Becc) Bridges, Undergraduate Student, Ph.D. SUNY Stony Brook, 2018.
Stan Brouns, Ph.D. Wageningen University, The Netherlands, TU Delft.
Overexpression of homologous proteins in Sulfolobus.
Ric Butler, Undergraduate Student
Aric Capel, Undergraduate Student, Fred Hutchinson Cancer Center
Ricky Chen, Undergraduate Researcher, M.D.
Diana Chung, Undergraduate Student
Aaron Daugherty, ASE High School Student, B.S. University of Richmond, Ph.D. Stanford, 2017.
Random Diessner, Undergraduate Student, Heritage University
Brook Drew, Undergraduate Student
Coyne Drummond, Undergraduate Student (Honors), Ph.D. University of Pittsburgh
Derick Falk, Undergraduate Student, The Medical College of Ohio
Daniel Flannery, Undergraduate Student.
Katrina Gates, Undergraduate Student
Jessica Grebenschikov, Undergraduate Student.
Maria Haruntunian, REU Student
Maria Herrera, Undergraduate Student, OHSU Medical School.
Kimia Ighani, REU Undergraduate Student
Alex Jiminez, Undergraduate Student, OHSU
Molly Juhlin, Undergraduate Student and REU student, D.Pharm, OSU.
Hee-Cheol Kim, Undergraduate Student
Jennifer Kuo , Undergraduate Student, MD program at U. Fl.
Matt Lambert, Undergraduate Student, Ph.D. program at WSU.
Sun Jin Lee, Undergraduate Student, Yale
Linda Lin, High School Student, Harvard
Caleb Marceau, Undergraduate Student (Honors), NIH UGSP Fellow, Ph.D. Stanford, 2018.
Blandine Monel, International Student Intern, Harvard Medical School.
David Montelongo, REU Student
Stephen Morris, Undergraduate Student, J.D.
Andrew Myhra, Undergraduate Student
Liliana Nankova, High School Student, Reed College
Jennifer Newsted, Undergraduate Student, U.Nevada, Las Vegas
Sarah Parish, Undergraduate Student
Nicole Paterson, Undergraduate Student, OHSU
Katrina Peterson, High School Student. Yale.
Andrew Platt, High School Student Brown University
Adam Sandes, Undergraduate Student, OHSU
Anja Schweier, M.S. Julius Maximilians-Universität, Würzburg, Germany
Thesis: Über konjugative Plasmide in Sulfolobus spp.
Currently at Roche Diagnostics
Beth Scott, Undergraduate Student, U. Arizona
Michelle Thayer, Undergraduate Researcher. Ph.D. Program at UCLA
Recipient of Undergraduate Research and Creativity Grant, Portland State University, 2006-2007
Ashley Vassilaros, Undergraduate Student.
Karen Wallace, Undergrauate Student.
Daniel Wark, Undergraduate Student
Laura White, Undergraduate Student (Honors), Ph.D. Program at OSHU
Carrie Widman (Brandon), Undergraduate Researcher, D.Pharm. Pacific University
Kameron Witham, Undergraduate Researcher, pursuing Masters in Mindfulness-based Transpersonal Counseling.
Joel Womack, Undergraduate Student, MD.
Caroline Zaoui, Undergraduate Student, U. Braunschweig, Germany
Yujie Zeng, High School Student, Columbia University
Luisa Zoeller, Undergraduate Student
B.S. Biology, Portland State University
Courtney Micheletti
B.S. Biology, Portland State, 2018
Parasite egg preservation ("poopy worms").
Plants, hiking, fishing and generally being a wilderness woman.
Research Technician at OHSU
Amber Maluenda
B.S. Biology, Portland State, 2020
BUILD EXITO Scholar
Crucivirus capsid protein expression
Hanging out with my daughter and crocheting.
ASE High School Student
Lena Nguyen
B.S. Biology, Portland State, 2017
SSV mutant infectivity.
Pokémon hunting and hiking.
James Musser
B.S. Biology, Portland State, 2019
Sulfurisphaera stuff
Hiking with my dog and that's it.
Diana Demchenko
B.S. Biology, Portland State, 2019
2017 Built Exito Scholar , 2018 Lester Newman Scholar
Long-term storage of virus particles, antiviral properties of nanoparticles, Saccharolobus bioinformatics.
Chicken hugging enthusiast.
Camden Hoover
B.S. Newman University, 2019
2018 REU Student
Worked on parasitic worm egg preservation and imaging. Soon to start graduate school.
Swati Pandruvada
A former REU student from Case Western, Swati likes to spend her summers with us studying parasitic worm egg preservation. Swati started medical school in the Fall of 2019.
Ahn Le-Cook
B.S. Biology, Portland State, 2016
Studying a new Sulfurisphaera species
Watching sci-fi and cooking. Now working at the VA Medical Center in Portland as a lab technician.